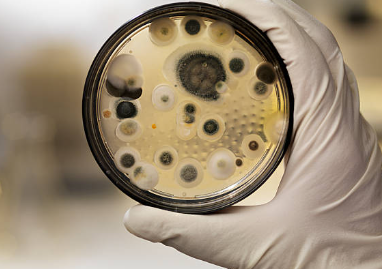

- 곰팡이 제거방법 완벽 정리(feat 장소별 곰팡이 제거방법) 목차
곰팡이 제거방법 완전정리
곰팡이는 한 번 생기면 “눈에 보이는 것만 닦아내면 끝”이라고 생각하기 쉬운데요. 실제로는 표면 아래나 틈새에 뿌리처럼 퍼져 있는 경우가 많아서, 대충 닦으면 금방 다시 올라옵니다. 그래서 곰팡이 제거는 “원인 파악 → 안전 준비 → 상황별 제거 → 재발 방지” 순서로 차근차근하는 게 가장 확실해요.

아래 내용은 집에서 많이 생기는 곰팡이 상황을 기준으로, 누구나 따라 하기 쉽게 아주 자세하게 정리해 드릴게요.
곰팡이가 생기는 진짜 이유부터 알아두기
곰팡이는 3가지만 맞으면 생깁니다.
습기, 온도, 먹이(먼지·비누찌꺼기·벽지풀·피지 등)예요.
- 습기
욕실, 베란다, 창가, 장롱 뒤, 싱크대 하부장처럼 공기가 잘 안 통하는 곳에서 습기가 오래 머물면 곰팡이가 좋아합니다. - 결로
겨울철창문 주변, 외벽 쪽 벽면, 침대 머리맡 벽처럼 차가운 면에 실내 따뜻한 공기가 닿으면 물방울이 맺히고, 그게 반복되면 벽지가 젖어서 곰팡이가 생겨요. - 누수
천장 모서리, 벽 중간이 얼룩처럼 젖는다, 비 오는 날만 심해진다, 아래층에서 냄새가 올라온다 같은 경우는 단순 곰팡이 청소로 끝나지 않을 수 있어요. 물이 들어오는 길을 막지 않으면 계속 생깁니다.
그래서 곰팡이 제거방법의 핵심은 “곰팡이를 없애는 것”과 “습기가 다시 쌓이지 않게 만드는 것”을 함께 하는 거예요.
곰팡이 제거 전에 꼭 해야 하는 안전 준비
곰팡이 제거할 때는 눈, 호흡기, 피부를 보호하는 게 정말 중요합니다. 냄새도 강하고 자극도 크거든요.
- 환기
창문을 활짝 열고, 가능하면 환풍기까지 같이 켜주세요. 작은 공간이라면 문을 닫고 창문 있는 방향으로 공기가 빠져나가게 만드는 게 좋아요. - 보호장비
마스크는 가능하면 KF94급 이상이 좋고, 고무장갑은 꼭 끼세요. 눈이 예민하시면 보호안경까지 하면 더 안전합니다. - 섞어 쓰지 않기
락스(염소계 표백제)와 산성 제품(식초, 화장실 산성세정제)을 섞으면 유해가스가 생길 수 있어요. 절대 같이 쓰지 마세요.
곰팡이 제거방법을 여러 개 쓰더라도 한 번에 하나만, 충분히 헹군 뒤 다음 단계로 넘어가야 합니다.
곰팡이 제거제 선택 기준
곰팡이를 없애는 방법은 크게 네 가지로 나뉩니다.
어디에 생겼는지에 따라 선택이 달라져요.
- 염소계 표백제(락스 계열)
욕실 타일 줄눈, 실리콘, 배수구 주변에 강력합니다.
단점은 냄새가 강하고 변색 위험이 있어요. 옷이나 수건에 튀면 탈색됩니다. - 과산화수소(산소계)
염소 냄새가 비교적 적고, 일부 소재에는 덜 자극적입니다.
단, 곰팡이가 깊게 먹은 실리콘에는 염소계가 더 잘 듣는 편이에요. - 알코올(에탄올)
표면 살균과 물기 제거에 도움이 됩니다.
하지만 이미 검게 번진 곰팡이 “얼룩 제거”에는 한계가 있어요. - 베이킹소다, 중성세제
기름때·비누 때·먼지 같은 “먹이”를 먼저 제거하는 데 좋습니다.
곰팡이 자체를 죽이는 힘은 약하니까, 보조 단계로 생각하시면 됩니다.
장소별 곰팡이 제거방법: 욕실(타일, 줄눈, 실리콘)
욕실은 곰팡이의 본진이라고 해도 과언이 아니죠. 하지만 순서만 지키면 깔끔하게 정리됩니다.
1단계: 비누 때부터 제거하기
곰팡이는 비누찌꺼기와 물때 위에서 더 잘 자랍니다.
먼저 샤워부스, 타일을 중성세제나 욕실세정제로 닦아 물때를 걷어내 주세요.
이 과정을 건너뛰면 곰팡이 제거제가 표면 때에 막혀서 효과가 떨어집니다.
2단계: 줄눈 곰팡이 제거
줄눈에 검은 점처럼 박힌 곰팡이는 제거제가 오래 닿아야 빠져요.
방법
- 분무형 곰팡이 제거제를 줄눈에 충분히 뿌립니다.
- 키친타월을 줄눈 위에 덮고, 그 위에 다시 한번 뿌려 적셔주세요.
- 20분에서 1시간 정도 두었다가, 솔로 살살 문질러 헹굽니다.
포인트
키친타월이 줄눈에 “붙어 있는 시간”이 길수록 곰팡이 제거 효과가 확 올라갑니다.
3단계: 실리콘 곰팡이 제거
실리콘은 곰팡이가 속까지 파고드는 경우가 많아요.
방법
- 실리콘에 제거제를 바르고 키친타월로 덮어 밀착
- 1시간 정도 후 확인
- 남아 있으면 같은 과정을 한 번 더
주의
실리콘이 이미 오래돼서 갈라졌거나 내부까지 까맣게 변한 경우는, 제거해도 얼룩이 완전히 사라지지 않을 수 있어요. 이런 경우는 실리콘을 제거하고 재시공하는 게 재발까지 막는 가장 확실한 곰팡이 제거방법이 됩니다.
장소별 곰팡이 제거방법: 창문, 창틀, 방충망(결로 곰팡이)
창문 곰팡이는 겨울 결로 때문에 정말 많이 생기죠.
특히 창틀 틈새, 고무패킹 주변이 문제예요.
창틀 곰팡이 제거 순서
- 마른 상태에서 먼지 먼저 제거
먼지가 젖으면 진흙처럼 달라붙어서 더 힘들어요. 브러시나 마른걸레로 먼저 털어주세요. - 틈새 청소
칫솔, 면봉, 작은 솔로 레일 홈을 긁어내고, 물티슈나 걸레로 닦습니다. - 곰팡이 제거제 적용
창틀 소재가 플라스틱이면 비교적 괜찮지만, 도장면이나 나무에 가까운 소재는 변색될 수 있어요.
눈에 띄지 않는 곳에 먼저 테스트하고 사용하세요. - 물기 완전 제거
창틀 곰팡이 제거방법의 마지막은 “완전 건조”예요.
마른걸레로 닦고, 드라이어의 찬바람이나 선풍기로 말려주세요.
방충망은 이렇게
방충망 곰팡이는 먼지와 습기가 합쳐져 생깁니다.
분무로 적신 뒤 솔로 문지르고, 물로 헹군 후 완전히 말리는 게 중요해요.
방충망이 젖은 채로 있으면 곰팡이가 다시 생깁니다.
장소별 곰팡이 제거방법: 벽지 곰팡이(가장 까다로운 유형)
벽지 곰팡이는 “닦아내는 것” 자체보다, 벽이 왜 젖었는지를 잡는 게 핵심이에요.
벽지 속 석고보드까지 젖었으면 겉만 지워도 다시 올라옵니다.
벽지 곰팡이 제거 기본 원칙
- 작은 면적: 표면 제거 + 건조 + 재발방지로 관리 가능
- 넓은 면적: 벽지 교체가 필요할 확률이 큼
- 눅눅한 느낌이 있다: 내부까지 젖었을 가능성 높음
벽지 곰팡이 제거방법(초기, 작은 면적)
- 마른걸레로 톡톡 닦기
문지르면 포자가 퍼질 수 있어요. 살살 찍듯이 닦습니다. - 알코올을 천에 묻혀 살균 닦기
직접 벽지에 흥건히 뿌리면 벽지가 울 수 있으니, 천에 묻혀서 닦는 쪽이 안전합니다. - 충분히 건조
제습기 또는 선풍기를 벽 쪽으로 오래 돌려주세요.
벽지 곰팡이 제거방법에서 이 단계가 빠지면 재발이 거의 확정이에요.
벽지 곰팡이가 자꾸 반복될 때
- 침대나 장롱이 벽에 딱 붙어 있다
- 외벽 쪽에 가구를 두었다
- 창문 결로가 심하다
이런 경우라면, 가구를 5~10cm만 띄워도 공기 흐름이 생겨서 곰팡이가 확 줄어듭니다.
장소별 곰팡이 제거방법: 옷장, 신발장, 장롱 뒤






이런 곳은 곰팡이가 “조용히 크게” 번지는 곳이에요.
냄새로 먼저 느끼는 경우가 많죠.
장롱·옷장 곰팡이 제거 순서
- 물건 다 꺼내기
안 꺼내고 대충 닦으면 안쪽에 남아있던 습기와 포자가 그대로 남습니다. - 내부를 마른걸레로 닦고, 알코올로 살균
나무 장롱은 물기를 싫어하니, 젖은 걸레보다 알코올을 묻힌 천으로 가볍게 닦는 게 좋습니다. - 문을 열어 환기 + 선풍기 바람
2~3시간만 해도 훨씬 좋아져요. 가능하면 반나절이면 더 좋고요. - 옷과 이불은 따로 관리
곰팡이 냄새가 밴 옷은 세탁만으로 안 빠지는 경우가 있어요.
세탁 후 완전 건조, 햇볕 건조가 도움이 됩니다.
곰팡이 제거 후 재발을 막는 관리법
곰팡이 제거방법을 아무리 잘해도, 습도가 다시 높아지면 또 생깁니다.
재발 방지는 습기 관리가 전부라고 보셔도 돼요.
1) 습도 목표를 정하기
실내 습도는 대체로 40~60% 정도가 무난합니다.
겨울엔 40~50%도 충분하고, 여름 장마철엔 50~60% 유지가 현실적이에요.
2) 욕실은 “마무리 루틴”이 중요
샤워 후
- 물기 스퀴지로 한번 쓸기
- 바닥 물기 닦기
- 환풍기 30분 이상 돌리기
이 세 가지만 해도 욕실 곰팡이는 확 줄어듭니다.
3) 창문 결로 줄이기
- 아침에 짧게라도 환기
- 창문에 맺힌 물방울 닦기
- 외벽 쪽 가구 띄우기
이게 가장 현실적인 곰팡이 예방 방법이에요.
4) 자주 생기는 곳은 “주 1회 점검”
줄눈, 실리콘, 창틀은 곰팡이 재발이 빠르니
주 1회만 눈으로 점검해도 큰 곰팡이를 막을 수 있어요.
초기에 발견하면 제거도 훨씬 쉽습니다.
곰팡이 제거가 어려운 경우: 이런 상황은 따로 봐야 해요

다음 중 하나라도 해당하면, 단순한 곰팡이 제거방법만으로는 해결이 어렵거나, 원인 해결이 먼저일 수 있어요.
- 천장이나 벽이 계속 젖어 있다
- 벽을 만지면 차갑고 눅눅하다
- 비가 오면 얼룩이 번진다
- 곰팡이 범위가 급격히 넓어진다
- 냄새가 아주 심하고 머리가 아프다
이런 경우는 누수, 단열 문제, 환기 구조 문제일 수 있습니다.
겉만 지우기보다 원인부터 잡아야 재발이 안 됩니다.
곰팡이 제거방법 핵심만 다시 정리









- 곰팡이는 표면만 닦으면 다시 올라오기 쉽다
- 안전하게 환기하고, 제품은 절대 섞지 않는다
- 욕실은 키친타월 밀착 방식이 효과가 좋다
- 창틀은 먼지 먼저, 그다음 제거, 마지막은 완전 건조
- 벽지는 건조가 생명이고, 반복되면 습기 원인을 잡아야 한다
- 재발 방지는 습도 관리와 환기, 물기 제거 습관이 핵심이다









지금까지 곰팡이 제거방법 관련하여 알아보았습니다.
다음에 또 도움 되는 글 가지고 돌아오겠습니다.
